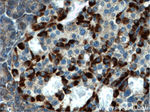
CHIT1 Antibody in Immunohistochemistry (Paraffin) (IHC (P))
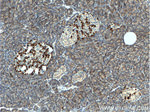
CHIT1 Antibody in Immunohistochemistry (Paraffin) (IHC (P))

Search
Proteintech
CHIT1 Polyclonal Antibody
{{$productOrderCtrl.translations['antibody.pdp.commerceCard.promotion.promotions']}}
{{$productOrderCtrl.translations['antibody.pdp.commerceCard.promotion.viewpromo']}}
{{$productOrderCtrl.translations['antibody.pdp.commerceCard.promotion.promocode']}}: {{promo.promoCode}} {{promo.promoTitle}} {{promo.promoDescription}}. {{$productOrderCtrl.translations['antibody.pdp.commerceCard.promotion.learnmore']}}
产品信息
21432-1-AP
种属反应
宿主/亚型
分类
类型
抗原
偶联物
形式
浓度
规格
纯化类型
保存液
内含物
保存条件
运输条件
产品详细信息
Immunogen sequence: QTFVNSAIR FLRKYSFDGL DLDWEYPGSQ GSPAVDKERF TTLVQDLANA FQQEAQTSGK ERLLLSAAVP AGQTYVDAGY EVDKIAQNLD FVNLMAYDFH GSWEKVTGHN SPLYKRQEES GAAASLNVDA AVQQWLQKGT PASKLILGMP TYGRSFTLAS SSDTRVGAPA TGSGTPGPFT KEGGMLAYYE VCSWKGATKQ RIQDQKVPYI FRDNQWVGFD DVESFKTKVS YLKQKGLGGA MVWALDLDDF AGFSCNQGRY PLIQTLRQEL SLPYLPSGTP ELEVPKPGQP SEPEHGPSPG QDTFCQGKAD GLYPNPRERS SFYSCAGGRL FQQSCPTGLV FSNSCKCCTW N (117-466 aa encoded by BC103695)
靶标信息
Chitotriosidase is secreted by activated human macrophages and is markedly elevated in plasma of Gaucher disease patients. The expression of chitotriosidase occurs only at a late stage of differentiation of monocytes to activated macrophages in culture. Human macrophages can synthesize a functional chitotriosidase, a highly conserved enzyme with a strongly regulated expression. This enzyme may play a role in the degradation of chitin-containing pathogens.
仅用于科研。不用于诊断过程。未经明确授权不得转售。
篇参考文献 (0)
生物信息学
蛋白别名: chitinase 1 (chitotriosidase); Chitinase-1; Chitotriosidase; Chitotriosidase-1; EC 3.2.1.14; FLJ00314; MGC125322; plasma methylumbelliferyl tetra-N-acetylchitotetraoside hydrolase; unnamed protein product
基因别名: CHI3; CHIT; CHIT1; CHITD
UniProt ID: (Human) Q13231
Entrez Gene ID: (Human) 1118